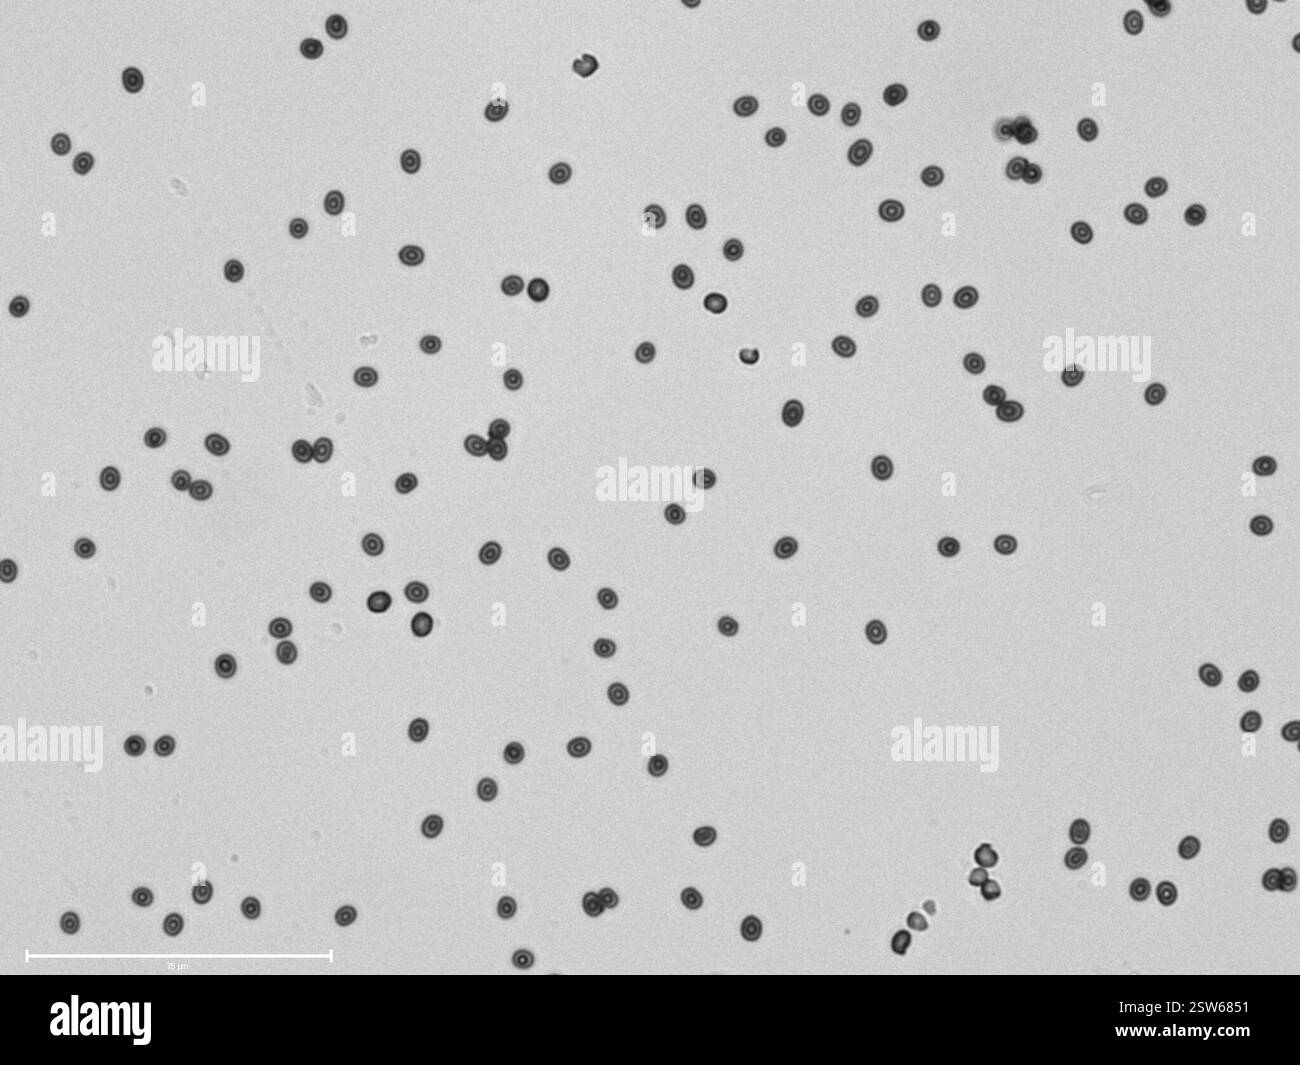
Pflasterpilz (Agaricus bitorquis), Fungi, Charles St, Cambridge, MA, US, wächst aus einem Riss zwischen dem Bürgersteig und einer Wand 15 cm Kappendurchmesser Brauner Sporendruck durchschnittlicher Sporendruck 4.9μm x 4.3μm Stockfoto

Brown mushroom Schwarz-Weiß-Archivfotos
 Kastanienbraune Kappe. Pilz auf dem Waldboden mit Moos und Kiefernnadeln. Essbare Pilze im Wald gesammelt. Foto aus der Natur Stockfotohttps://www.alamy.de/image-license-details/?v=1https://www.alamy.de/kastanienbraune-kappe-pilz-auf-dem-waldboden-mit-moos-und-kiefernnadeln-essbare-pilze-im-wald-gesammelt-foto-aus-der-natur-image489101230.html
Kastanienbraune Kappe. Pilz auf dem Waldboden mit Moos und Kiefernnadeln. Essbare Pilze im Wald gesammelt. Foto aus der Natur Stockfotohttps://www.alamy.de/image-license-details/?v=1https://www.alamy.de/kastanienbraune-kappe-pilz-auf-dem-waldboden-mit-moos-und-kiefernnadeln-essbare-pilze-im-wald-gesammelt-foto-aus-der-natur-image489101230.htmlRF2KBMDH2–Kastanienbraune Kappe. Pilz auf dem Waldboden mit Moos und Kiefernnadeln. Essbare Pilze im Wald gesammelt. Foto aus der Natur
 Pilzmenü Karte Stockfotohttps://www.alamy.de/image-license-details/?v=1https://www.alamy.de/stockfoto-pilzmenu-karte-123198015.html
Pilzmenü Karte Stockfotohttps://www.alamy.de/image-license-details/?v=1https://www.alamy.de/stockfoto-pilzmenu-karte-123198015.htmlRMH4C493–Pilzmenü Karte
 Im Herbst unter dem Motto Bild mit Schnecke auf Pilz Wald mit Blättern und Moos Stockfotohttps://www.alamy.de/image-license-details/?v=1https://www.alamy.de/stockfoto-im-herbst-unter-dem-motto-bild-mit-schnecke-auf-pilz-wald-mit-blattern-und-moos-104979979.html
Im Herbst unter dem Motto Bild mit Schnecke auf Pilz Wald mit Blättern und Moos Stockfotohttps://www.alamy.de/image-license-details/?v=1https://www.alamy.de/stockfoto-im-herbst-unter-dem-motto-bild-mit-schnecke-auf-pilz-wald-mit-blattern-und-moos-104979979.htmlRFG2P70Y–Im Herbst unter dem Motto Bild mit Schnecke auf Pilz Wald mit Blättern und Moos
 Braune Clamshell-Pilze stehen zum Braten auf. Auch bekannt als buna-himeji oder Brown Beech Pilzes. Biologisch, gewirtschaftet aus den Wäldern von NJ, USA Stockfotohttps://www.alamy.de/image-license-details/?v=1https://www.alamy.de/braune-clamshell-pilze-stehen-zum-braten-auf-auch-bekannt-als-buna-himeji-oder-brown-beech-pilzes-biologisch-gewirtschaftet-aus-den-waldern-von-nj-usa-image484701589.html
Braune Clamshell-Pilze stehen zum Braten auf. Auch bekannt als buna-himeji oder Brown Beech Pilzes. Biologisch, gewirtschaftet aus den Wäldern von NJ, USA Stockfotohttps://www.alamy.de/image-license-details/?v=1https://www.alamy.de/braune-clamshell-pilze-stehen-zum-braten-auf-auch-bekannt-als-buna-himeji-oder-brown-beech-pilzes-biologisch-gewirtschaftet-aus-den-waldern-von-nj-usa-image484701589.htmlRM2K4G1R1–Braune Clamshell-Pilze stehen zum Braten auf. Auch bekannt als buna-himeji oder Brown Beech Pilzes. Biologisch, gewirtschaftet aus den Wäldern von NJ, USA
 Detail eines riesigen braunen und weißen Pilzes Macrolepiota procera Stockfotohttps://www.alamy.de/image-license-details/?v=1https://www.alamy.de/detail-eines-riesigen-braunen-und-weissen-pilzes-macrolepiota-procera-image375929786.html
Detail eines riesigen braunen und weißen Pilzes Macrolepiota procera Stockfotohttps://www.alamy.de/image-license-details/?v=1https://www.alamy.de/detail-eines-riesigen-braunen-und-weissen-pilzes-macrolepiota-procera-image375929786.htmlRF2CRH27P–Detail eines riesigen braunen und weißen Pilzes Macrolepiota procera
 Schneiden Sie Pilze zum Trocknen Stockfotohttps://www.alamy.de/image-license-details/?v=1https://www.alamy.de/stockfoto-schneiden-sie-pilze-zum-trocknen-58206143.html
Schneiden Sie Pilze zum Trocknen Stockfotohttps://www.alamy.de/image-license-details/?v=1https://www.alamy.de/stockfoto-schneiden-sie-pilze-zum-trocknen-58206143.htmlRFDAKEER–Schneiden Sie Pilze zum Trocknen
 Pilze - Garten Pilz Stockfotohttps://www.alamy.de/image-license-details/?v=1https://www.alamy.de/pilze-garten-pilz-image330568593.html
Pilze - Garten Pilz Stockfotohttps://www.alamy.de/image-license-details/?v=1https://www.alamy.de/pilze-garten-pilz-image330568593.htmlRF2A5PKH5–Pilze - Garten Pilz
 Schnecke auf Pilz Stockfotohttps://www.alamy.de/image-license-details/?v=1https://www.alamy.de/stockfoto-schnecke-auf-pilz-80103713.html
Schnecke auf Pilz Stockfotohttps://www.alamy.de/image-license-details/?v=1https://www.alamy.de/stockfoto-schnecke-auf-pilz-80103713.htmlRFEJ912W–Schnecke auf Pilz
 Makrofotografie mit Pilzen Stockfotohttps://www.alamy.de/image-license-details/?v=1https://www.alamy.de/makrofotografie-mit-pilzen-image483321354.html
Makrofotografie mit Pilzen Stockfotohttps://www.alamy.de/image-license-details/?v=1https://www.alamy.de/makrofotografie-mit-pilzen-image483321354.htmlRF2K2958X–Makrofotografie mit Pilzen
 Abstraktes Muster mit Pilzstruktur für Design und Dekoration. Speisepilze-Schlange. Austernpilz-Makromuster. Stockfotohttps://www.alamy.de/image-license-details/?v=1https://www.alamy.de/abstraktes-muster-mit-pilzstruktur-fur-design-und-dekoration-speisepilze-schlange-austernpilz-makromuster-image502554506.html
Abstraktes Muster mit Pilzstruktur für Design und Dekoration. Speisepilze-Schlange. Austernpilz-Makromuster. Stockfotohttps://www.alamy.de/image-license-details/?v=1https://www.alamy.de/abstraktes-muster-mit-pilzstruktur-fur-design-und-dekoration-speisepilze-schlange-austernpilz-makromuster-image502554506.htmlRM2M5H9B6–Abstraktes Muster mit Pilzstruktur für Design und Dekoration. Speisepilze-Schlange. Austernpilz-Makromuster.
 The Woodlands, TX USA - Mar 20, 2018 - Pilzzucht in Baum in B&W Stockfotohttps://www.alamy.de/image-license-details/?v=1https://www.alamy.de/the-woodlands-tx-usa-mar-20-2018-pilzzucht-in-baum-in-bw-image218583855.html
The Woodlands, TX USA - Mar 20, 2018 - Pilzzucht in Baum in B&W Stockfotohttps://www.alamy.de/image-license-details/?v=1https://www.alamy.de/the-woodlands-tx-usa-mar-20-2018-pilzzucht-in-baum-in-bw-image218583855.htmlRFPKH9X7–The Woodlands, TX USA - Mar 20, 2018 - Pilzzucht in Baum in B&W
 Pilz in Schwarzweiß Stockfotohttps://www.alamy.de/image-license-details/?v=1https://www.alamy.de/pilz-in-schwarzweiss-image484484260.html
Pilz in Schwarzweiß Stockfotohttps://www.alamy.de/image-license-details/?v=1https://www.alamy.de/pilz-in-schwarzweiss-image484484260.htmlRF2K464H8–Pilz in Schwarzweiß
 Gruppe von Pilzen mit schwarz-weiß-Effekt Stockfotohttps://www.alamy.de/image-license-details/?v=1https://www.alamy.de/gruppe-von-pilzen-mit-schwarz-weiss-effekt-image431535622.html
Gruppe von Pilzen mit schwarz-weiß-Effekt Stockfotohttps://www.alamy.de/image-license-details/?v=1https://www.alamy.de/gruppe-von-pilzen-mit-schwarz-weiss-effekt-image431535622.htmlRF2G2242E–Gruppe von Pilzen mit schwarz-weiß-Effekt
 Pilz im Laubwald entdeckt beim Schauen. Schöne Lichtstimmung und befreit. Stockfotohttps://www.alamy.de/image-license-details/?v=1https://www.alamy.de/pilz-im-laubwald-entdeckt-beim-schauen-schone-lichtstimmung-und-befreit-image454732552.html
Pilz im Laubwald entdeckt beim Schauen. Schöne Lichtstimmung und befreit. Stockfotohttps://www.alamy.de/image-license-details/?v=1https://www.alamy.de/pilz-im-laubwald-entdeckt-beim-schauen-schone-lichtstimmung-und-befreit-image454732552.htmlRF2HBPT08–Pilz im Laubwald entdeckt beim Schauen. Schöne Lichtstimmung und befreit.
 Kleine natürliche ungenießbare weiße Farbe Pilz wächst auf dem Reisfeld Boden. Nahaufnahme niedrigen Winkel schwarz und weiß Foto. Schönheit der Natur Stockfotohttps://www.alamy.de/image-license-details/?v=1https://www.alamy.de/kleine-naturliche-ungeniessbare-weisse-farbe-pilz-wachst-auf-dem-reisfeld-boden-nahaufnahme-niedrigen-winkel-schwarz-und-weiss-foto-schonheit-der-natur-image421190157.html
Kleine natürliche ungenießbare weiße Farbe Pilz wächst auf dem Reisfeld Boden. Nahaufnahme niedrigen Winkel schwarz und weiß Foto. Schönheit der Natur Stockfotohttps://www.alamy.de/image-license-details/?v=1https://www.alamy.de/kleine-naturliche-ungeniessbare-weisse-farbe-pilz-wachst-auf-dem-reisfeld-boden-nahaufnahme-niedrigen-winkel-schwarz-und-weiss-foto-schonheit-der-natur-image421190157.htmlRF2FD6T9H–Kleine natürliche ungenießbare weiße Farbe Pilz wächst auf dem Reisfeld Boden. Nahaufnahme niedrigen Winkel schwarz und weiß Foto. Schönheit der Natur
 Wilde Pilze in einem wunderschönen Herbstwald. Herbstzeit im Wald Stockfotohttps://www.alamy.de/image-license-details/?v=1https://www.alamy.de/wilde-pilze-in-einem-wunderschonen-herbstwald-herbstzeit-im-wald-image499942699.html
Wilde Pilze in einem wunderschönen Herbstwald. Herbstzeit im Wald Stockfotohttps://www.alamy.de/image-license-details/?v=1https://www.alamy.de/wilde-pilze-in-einem-wunderschonen-herbstwald-herbstzeit-im-wald-image499942699.htmlRF2M1AA0B–Wilde Pilze in einem wunderschönen Herbstwald. Herbstzeit im Wald
 Wiesbaden Hessen Deutschland Wald im Herbst Stockfotohttps://www.alamy.de/image-license-details/?v=1https://www.alamy.de/wiesbaden-hessen-deutschland-wald-im-herbst-image387857162.html
Wiesbaden Hessen Deutschland Wald im Herbst Stockfotohttps://www.alamy.de/image-license-details/?v=1https://www.alamy.de/wiesbaden-hessen-deutschland-wald-im-herbst-image387857162.htmlRF2DF0BNE–Wiesbaden Hessen Deutschland Wald im Herbst
 Frische Pilze aus der Nähe Stockfotohttps://www.alamy.de/image-license-details/?v=1https://www.alamy.de/frische-pilze-aus-der-nahe-image682886000.html
Frische Pilze aus der Nähe Stockfotohttps://www.alamy.de/image-license-details/?v=1https://www.alamy.de/frische-pilze-aus-der-nahe-image682886000.htmlRF3BK041M–Frische Pilze aus der Nähe
 Zerbrochene Pilze auf einem Waldboden Stockfotohttps://www.alamy.de/image-license-details/?v=1https://www.alamy.de/zerbrochene-pilze-auf-einem-waldboden-image430453879.html
Zerbrochene Pilze auf einem Waldboden Stockfotohttps://www.alamy.de/image-license-details/?v=1https://www.alamy.de/zerbrochene-pilze-auf-einem-waldboden-image430453879.htmlRF2G08T8R–Zerbrochene Pilze auf einem Waldboden
 Schuss von Pilzen, die auf einem moosigen Baumstamm im Wald wachsen. Selektiv auf die nächsten Ränder der Pilze fokussiert und von der Sonne beleuchtet. Stockfotohttps://www.alamy.de/image-license-details/?v=1https://www.alamy.de/schuss-von-pilzen-die-auf-einem-moosigen-baumstamm-im-wald-wachsen-selektiv-auf-die-nachsten-rander-der-pilze-fokussiert-und-von-der-sonne-beleuchtet-image442965449.html
Schuss von Pilzen, die auf einem moosigen Baumstamm im Wald wachsen. Selektiv auf die nächsten Ränder der Pilze fokussiert und von der Sonne beleuchtet. Stockfotohttps://www.alamy.de/image-license-details/?v=1https://www.alamy.de/schuss-von-pilzen-die-auf-einem-moosigen-baumstamm-im-wald-wachsen-selektiv-auf-die-nachsten-rander-der-pilze-fokussiert-und-von-der-sonne-beleuchtet-image442965449.htmlRF2GMJPXH–Schuss von Pilzen, die auf einem moosigen Baumstamm im Wald wachsen. Selektiv auf die nächsten Ränder der Pilze fokussiert und von der Sonne beleuchtet.
 Blick auf eine Kastanie, Herbst auf den Boden fallen und den Tieren als Nahrung dienen Stockfotohttps://www.alamy.de/image-license-details/?v=1https://www.alamy.de/blick-auf-eine-kastanie-herbst-auf-den-boden-fallen-und-den-tieren-als-nahrung-dienen-image363316952.html
Blick auf eine Kastanie, Herbst auf den Boden fallen und den Tieren als Nahrung dienen Stockfotohttps://www.alamy.de/image-license-details/?v=1https://www.alamy.de/blick-auf-eine-kastanie-herbst-auf-den-boden-fallen-und-den-tieren-als-nahrung-dienen-image363316952.htmlRF2C32EDC–Blick auf eine Kastanie, Herbst auf den Boden fallen und den Tieren als Nahrung dienen
 Im Herbst unter dem Motto Bild mit Schnecke auf Pilz Wald mit Blättern und Moos Stockfotohttps://www.alamy.de/image-license-details/?v=1https://www.alamy.de/stockfoto-im-herbst-unter-dem-motto-bild-mit-schnecke-auf-pilz-wald-mit-blattern-und-moos-104980011.html
Im Herbst unter dem Motto Bild mit Schnecke auf Pilz Wald mit Blättern und Moos Stockfotohttps://www.alamy.de/image-license-details/?v=1https://www.alamy.de/stockfoto-im-herbst-unter-dem-motto-bild-mit-schnecke-auf-pilz-wald-mit-blattern-und-moos-104980011.htmlRFG2P723–Im Herbst unter dem Motto Bild mit Schnecke auf Pilz Wald mit Blättern und Moos
 King Oyster-Pilze sind fleischige Pilze, die zum Braten aufstehen. Sie haben eine pikante oder Umami-Qualität. Ein natürlicher Ersatz für Fleisch. Organisch Stockfotohttps://www.alamy.de/image-license-details/?v=1https://www.alamy.de/king-oyster-pilze-sind-fleischige-pilze-die-zum-braten-aufstehen-sie-haben-eine-pikante-oder-umami-qualitat-ein-naturlicher-ersatz-fur-fleisch-organisch-image484701579.html
King Oyster-Pilze sind fleischige Pilze, die zum Braten aufstehen. Sie haben eine pikante oder Umami-Qualität. Ein natürlicher Ersatz für Fleisch. Organisch Stockfotohttps://www.alamy.de/image-license-details/?v=1https://www.alamy.de/king-oyster-pilze-sind-fleischige-pilze-die-zum-braten-aufstehen-sie-haben-eine-pikante-oder-umami-qualitat-ein-naturlicher-ersatz-fur-fleisch-organisch-image484701579.htmlRM2K4G1PK–King Oyster-Pilze sind fleischige Pilze, die zum Braten aufstehen. Sie haben eine pikante oder Umami-Qualität. Ein natürlicher Ersatz für Fleisch. Organisch
 Gruppe von Pilzen Stockfotohttps://www.alamy.de/image-license-details/?v=1https://www.alamy.de/gruppe-von-pilzen-image450422218.html
Gruppe von Pilzen Stockfotohttps://www.alamy.de/image-license-details/?v=1https://www.alamy.de/gruppe-von-pilzen-image450422218.htmlRM2H4PE3P–Gruppe von Pilzen
 Bereiten Sie Pilze zum Trocknen Stockfotohttps://www.alamy.de/image-license-details/?v=1https://www.alamy.de/stockfoto-bereiten-sie-pilze-zum-trocknen-58206146.html
Bereiten Sie Pilze zum Trocknen Stockfotohttps://www.alamy.de/image-license-details/?v=1https://www.alamy.de/stockfoto-bereiten-sie-pilze-zum-trocknen-58206146.htmlRFDAKEEX–Bereiten Sie Pilze zum Trocknen
 Bäume mit Pilzen. Blick von unten in den Himmel. Schwarz und Weiß. Stockfotohttps://www.alamy.de/image-license-details/?v=1https://www.alamy.de/baume-mit-pilzen-blick-von-unten-in-den-himmel-schwarz-und-weiss-image208121446.html
Bäume mit Pilzen. Blick von unten in den Himmel. Schwarz und Weiß. Stockfotohttps://www.alamy.de/image-license-details/?v=1https://www.alamy.de/baume-mit-pilzen-blick-von-unten-in-den-himmel-schwarz-und-weiss-image208121446.htmlRFP2GN0P–Bäume mit Pilzen. Blick von unten in den Himmel. Schwarz und Weiß.
 Monochromatisches Nahaufnahme von zwei verfallenden Fliege-Amanita-Pilzen im Wald Stockfotohttps://www.alamy.de/image-license-details/?v=1https://www.alamy.de/monochromatisches-nahaufnahme-von-zwei-verfallenden-fliege-amanita-pilzen-im-wald-image448865047.html
Monochromatisches Nahaufnahme von zwei verfallenden Fliege-Amanita-Pilzen im Wald Stockfotohttps://www.alamy.de/image-license-details/?v=1https://www.alamy.de/monochromatisches-nahaufnahme-von-zwei-verfallenden-fliege-amanita-pilzen-im-wald-image448865047.htmlRF2H27FXF–Monochromatisches Nahaufnahme von zwei verfallenden Fliege-Amanita-Pilzen im Wald
 Monochrome Diminutivus agaricus Agaricus diminutivus 16605 Stockfotohttps://www.alamy.de/image-license-details/?v=1https://www.alamy.de/monochrome-diminutivus-agaricus-agaricus-diminutivus-16605-image700505569.html
Monochrome Diminutivus agaricus Agaricus diminutivus 16605 Stockfotohttps://www.alamy.de/image-license-details/?v=1https://www.alamy.de/monochrome-diminutivus-agaricus-agaricus-diminutivus-16605-image700505569.htmlRF3CKJP01–Monochrome Diminutivus agaricus Agaricus diminutivus 16605
 Pilze auf dunklem Hintergrund Stockfotohttps://www.alamy.de/image-license-details/?v=1https://www.alamy.de/pilze-auf-dunklem-hintergrund-image210476188.html
Pilze auf dunklem Hintergrund Stockfotohttps://www.alamy.de/image-license-details/?v=1https://www.alamy.de/pilze-auf-dunklem-hintergrund-image210476188.htmlRFP6C0EM–Pilze auf dunklem Hintergrund
 Konzeptuelle Collage-Kunst einer Armbanduhr mit Pilz Stockfotohttps://www.alamy.de/image-license-details/?v=1https://www.alamy.de/konzeptuelle-collage-kunst-einer-armbanduhr-mit-pilz-image641521057.html
Konzeptuelle Collage-Kunst einer Armbanduhr mit Pilz Stockfotohttps://www.alamy.de/image-license-details/?v=1https://www.alamy.de/konzeptuelle-collage-kunst-einer-armbanduhr-mit-pilz-image641521057.htmlRM2S7KPJ9–Konzeptuelle Collage-Kunst einer Armbanduhr mit Pilz
 Schwarz-weißes Bild von britischen Wildpilzen und Pilzen in Hampstead, London. Stockfotohttps://www.alamy.de/image-license-details/?v=1https://www.alamy.de/schwarz-weisses-bild-von-britischen-wildpilzen-und-pilzen-in-hampstead-london-image487577889.html
Schwarz-weißes Bild von britischen Wildpilzen und Pilzen in Hampstead, London. Stockfotohttps://www.alamy.de/image-license-details/?v=1https://www.alamy.de/schwarz-weisses-bild-von-britischen-wildpilzen-und-pilzen-in-hampstead-london-image487577889.htmlRF2K972G1–Schwarz-weißes Bild von britischen Wildpilzen und Pilzen in Hampstead, London.
 Waldpilze Pilz mit einem Schlagschatten ausgeschnitten und isoliert auf einem weißen Hintergrund schwarz-weiß monochromes Bild Stockfotohttps://www.alamy.de/image-license-details/?v=1https://www.alamy.de/waldpilze-pilz-mit-einem-schlagschatten-ausgeschnitten-und-isoliert-auf-einem-weissen-hintergrund-schwarz-weiss-monochromes-bild-image365660318.html
Waldpilze Pilz mit einem Schlagschatten ausgeschnitten und isoliert auf einem weißen Hintergrund schwarz-weiß monochromes Bild Stockfotohttps://www.alamy.de/image-license-details/?v=1https://www.alamy.de/waldpilze-pilz-mit-einem-schlagschatten-ausgeschnitten-und-isoliert-auf-einem-weissen-hintergrund-schwarz-weiss-monochromes-bild-image365660318.htmlRF2C6W7D2–Waldpilze Pilz mit einem Schlagschatten ausgeschnitten und isoliert auf einem weißen Hintergrund schwarz-weiß monochromes Bild
 Sonnenschirm Pilz (Macrolepiota procera), gesunde wilde Pilz, Braga, Minho, Portugal. Stockfotohttps://www.alamy.de/image-license-details/?v=1https://www.alamy.de/sonnenschirm-pilz-macrolepiota-procera-gesunde-wilde-pilz-braga-minho-portugal-image330629624.html
Sonnenschirm Pilz (Macrolepiota procera), gesunde wilde Pilz, Braga, Minho, Portugal. Stockfotohttps://www.alamy.de/image-license-details/?v=1https://www.alamy.de/sonnenschirm-pilz-macrolepiota-procera-gesunde-wilde-pilz-braga-minho-portugal-image330629624.htmlRF2A5WDCT–Sonnenschirm Pilz (Macrolepiota procera), gesunde wilde Pilz, Braga, Minho, Portugal.
 Schwarz / weiß Foto von Pilz Anbau: Anbau von Austernpilzen vom laichen in Hof. Tiefenschärfe, Hintergrund Stockfotohttps://www.alamy.de/image-license-details/?v=1https://www.alamy.de/stockfoto-schwarz-weiss-foto-von-pilz-anbau-anbau-von-austernpilzen-vom-laichen-in-hof-tiefenscharfe-hintergrund-140063174.html
Schwarz / weiß Foto von Pilz Anbau: Anbau von Austernpilzen vom laichen in Hof. Tiefenschärfe, Hintergrund Stockfotohttps://www.alamy.de/image-license-details/?v=1https://www.alamy.de/stockfoto-schwarz-weiss-foto-von-pilz-anbau-anbau-von-austernpilzen-vom-laichen-in-hof-tiefenscharfe-hintergrund-140063174.htmlRFJ3TC06–Schwarz / weiß Foto von Pilz Anbau: Anbau von Austernpilzen vom laichen in Hof. Tiefenschärfe, Hintergrund
 Close-up auf der Unterseite eines Portobello Pilze ohne die zentrale Bedienhebel Stockfotohttps://www.alamy.de/image-license-details/?v=1https://www.alamy.de/stockfoto-close-up-auf-der-unterseite-eines-portobello-pilze-ohne-die-zentrale-bedienhebel-166522921.html
Close-up auf der Unterseite eines Portobello Pilze ohne die zentrale Bedienhebel Stockfotohttps://www.alamy.de/image-license-details/?v=1https://www.alamy.de/stockfoto-close-up-auf-der-unterseite-eines-portobello-pilze-ohne-die-zentrale-bedienhebel-166522921.htmlRFKJWNK5–Close-up auf der Unterseite eines Portobello Pilze ohne die zentrale Bedienhebel
 Wiesbaden Hessen Deutschland Wald im Herbst Stockfotohttps://www.alamy.de/image-license-details/?v=1https://www.alamy.de/wiesbaden-hessen-deutschland-wald-im-herbst-image387857833.html
Wiesbaden Hessen Deutschland Wald im Herbst Stockfotohttps://www.alamy.de/image-license-details/?v=1https://www.alamy.de/wiesbaden-hessen-deutschland-wald-im-herbst-image387857833.htmlRF2DF0CHD–Wiesbaden Hessen Deutschland Wald im Herbst
 Der seltene Genießbare Löwen Mähne Pilz/Hericium erinaceus/pruikzwam im Wald. Wunderschön strahlende und auffällige mit seiner weißen Farbe zwischen Aut Stockfotohttps://www.alamy.de/image-license-details/?v=1https://www.alamy.de/der-seltene-geniessbare-lowen-mahne-pilzhericium-erinaceuspruikzwam-im-wald-wunderschon-strahlende-und-auffallige-mit-seiner-weissen-farbe-zwischen-aut-image228118897.html
Der seltene Genießbare Löwen Mähne Pilz/Hericium erinaceus/pruikzwam im Wald. Wunderschön strahlende und auffällige mit seiner weißen Farbe zwischen Aut Stockfotohttps://www.alamy.de/image-license-details/?v=1https://www.alamy.de/der-seltene-geniessbare-lowen-mahne-pilzhericium-erinaceuspruikzwam-im-wald-wunderschon-strahlende-und-auffallige-mit-seiner-weissen-farbe-zwischen-aut-image228118897.htmlRFR73KYD–Der seltene Genießbare Löwen Mähne Pilz/Hericium erinaceus/pruikzwam im Wald. Wunderschön strahlende und auffällige mit seiner weißen Farbe zwischen Aut
 Kastanienbraune Kappe. Pilz auf dem Waldboden mit Moos und Kiefernnadeln. Essbare Pilze im Wald gesammelt. Foto aus der Natur Stockfotohttps://www.alamy.de/image-license-details/?v=1https://www.alamy.de/kastanienbraune-kappe-pilz-auf-dem-waldboden-mit-moos-und-kiefernnadeln-essbare-pilze-im-wald-gesammelt-foto-aus-der-natur-image548354670.html
Kastanienbraune Kappe. Pilz auf dem Waldboden mit Moos und Kiefernnadeln. Essbare Pilze im Wald gesammelt. Foto aus der Natur Stockfotohttps://www.alamy.de/image-license-details/?v=1https://www.alamy.de/kastanienbraune-kappe-pilz-auf-dem-waldboden-mit-moos-und-kiefernnadeln-essbare-pilze-im-wald-gesammelt-foto-aus-der-natur-image548354670.htmlRF2PT3KYA–Kastanienbraune Kappe. Pilz auf dem Waldboden mit Moos und Kiefernnadeln. Essbare Pilze im Wald gesammelt. Foto aus der Natur
 Schwarz-Weiß-Schuss, Macrolepiota procera oder Sonnenpilze auf Herbstwiese. Stockfotohttps://www.alamy.de/image-license-details/?v=1https://www.alamy.de/schwarz-weiss-schuss-macrolepiota-procera-oder-sonnenpilze-auf-herbstwiese-image442964118.html
Schwarz-Weiß-Schuss, Macrolepiota procera oder Sonnenpilze auf Herbstwiese. Stockfotohttps://www.alamy.de/image-license-details/?v=1https://www.alamy.de/schwarz-weiss-schuss-macrolepiota-procera-oder-sonnenpilze-auf-herbstwiese-image442964118.htmlRF2GMJN72–Schwarz-Weiß-Schuss, Macrolepiota procera oder Sonnenpilze auf Herbstwiese.
 Makro von abstrakten Wildpilzen in schwarz und weiß. Stockfotohttps://www.alamy.de/image-license-details/?v=1https://www.alamy.de/makro-von-abstrakten-wildpilzen-in-schwarz-und-weiss-image379266686.html
Makro von abstrakten Wildpilzen in schwarz und weiß. Stockfotohttps://www.alamy.de/image-license-details/?v=1https://www.alamy.de/makro-von-abstrakten-wildpilzen-in-schwarz-und-weiss-image379266686.htmlRM2D112EP–Makro von abstrakten Wildpilzen in schwarz und weiß.
 Im Herbst unter dem Motto Bild mit Schnecke auf Pilz Wald mit Blättern und Moos Stockfotohttps://www.alamy.de/image-license-details/?v=1https://www.alamy.de/stockfoto-im-herbst-unter-dem-motto-bild-mit-schnecke-auf-pilz-wald-mit-blattern-und-moos-104979967.html
Im Herbst unter dem Motto Bild mit Schnecke auf Pilz Wald mit Blättern und Moos Stockfotohttps://www.alamy.de/image-license-details/?v=1https://www.alamy.de/stockfoto-im-herbst-unter-dem-motto-bild-mit-schnecke-auf-pilz-wald-mit-blattern-und-moos-104979967.htmlRFG2P70F–Im Herbst unter dem Motto Bild mit Schnecke auf Pilz Wald mit Blättern und Moos
 King Oyster-Pilze sind fleischige Pilze, die zum Braten aufstehen. Sie haben eine pikante oder Umami-Qualität. Ein natürlicher Ersatz für Fleisch. Organisch Stockfotohttps://www.alamy.de/image-license-details/?v=1https://www.alamy.de/king-oyster-pilze-sind-fleischige-pilze-die-zum-braten-aufstehen-sie-haben-eine-pikante-oder-umami-qualitat-ein-naturlicher-ersatz-fur-fleisch-organisch-image484701573.html
King Oyster-Pilze sind fleischige Pilze, die zum Braten aufstehen. Sie haben eine pikante oder Umami-Qualität. Ein natürlicher Ersatz für Fleisch. Organisch Stockfotohttps://www.alamy.de/image-license-details/?v=1https://www.alamy.de/king-oyster-pilze-sind-fleischige-pilze-die-zum-braten-aufstehen-sie-haben-eine-pikante-oder-umami-qualitat-ein-naturlicher-ersatz-fur-fleisch-organisch-image484701573.htmlRM2K4G1PD–King Oyster-Pilze sind fleischige Pilze, die zum Braten aufstehen. Sie haben eine pikante oder Umami-Qualität. Ein natürlicher Ersatz für Fleisch. Organisch
 Großer Baumpilz. Studio-Shooting mit Pilzen. Stockfotohttps://www.alamy.de/image-license-details/?v=1https://www.alamy.de/grosser-baumpilz-studio-shooting-mit-pilzen-image469412702.html
Großer Baumpilz. Studio-Shooting mit Pilzen. Stockfotohttps://www.alamy.de/image-license-details/?v=1https://www.alamy.de/grosser-baumpilz-studio-shooting-mit-pilzen-image469412702.htmlRM2J7KGKA–Großer Baumpilz. Studio-Shooting mit Pilzen.
 Gesundes Essen auf den Tisch. Portrait von glücklich moderne Frau Koch Schürze tragen auf gelbem Hintergrund, die ein Gläschen mit mariniertem Gemüse und Pilze Stockfotohttps://www.alamy.de/image-license-details/?v=1https://www.alamy.de/stockfoto-gesundes-essen-auf-den-tisch-portrait-von-glucklich-moderne-frau-koch-schurze-tragen-auf-gelbem-hintergrund-die-ein-glaschen-mit-mariniertem-gemuse-und-pilze-170725120.html
Gesundes Essen auf den Tisch. Portrait von glücklich moderne Frau Koch Schürze tragen auf gelbem Hintergrund, die ein Gläschen mit mariniertem Gemüse und Pilze Stockfotohttps://www.alamy.de/image-license-details/?v=1https://www.alamy.de/stockfoto-gesundes-essen-auf-den-tisch-portrait-von-glucklich-moderne-frau-koch-schurze-tragen-auf-gelbem-hintergrund-die-ein-glaschen-mit-mariniertem-gemuse-und-pilze-170725120.htmlRFKWN5HM–Gesundes Essen auf den Tisch. Portrait von glücklich moderne Frau Koch Schürze tragen auf gelbem Hintergrund, die ein Gläschen mit mariniertem Gemüse und Pilze
 Gemeinsame Pilz ist für das Kochen. Die GAP hat ein helles grau-braune Farbe und Breite, flache Waage, vintage Strichzeichnung oder Gravur Abbildung. Stock Vektorhttps://www.alamy.de/image-license-details/?v=1https://www.alamy.de/gemeinsame-pilz-ist-fur-das-kochen-die-gap-hat-ein-helles-grau-braune-farbe-und-breite-flache-waage-vintage-strichzeichnung-oder-gravur-abbildung-image244493283.html
Gemeinsame Pilz ist für das Kochen. Die GAP hat ein helles grau-braune Farbe und Breite, flache Waage, vintage Strichzeichnung oder Gravur Abbildung. Stock Vektorhttps://www.alamy.de/image-license-details/?v=1https://www.alamy.de/gemeinsame-pilz-ist-fur-das-kochen-die-gap-hat-ein-helles-grau-braune-farbe-und-breite-flache-waage-vintage-strichzeichnung-oder-gravur-abbildung-image244493283.htmlRFT5NHJY–Gemeinsame Pilz ist für das Kochen. Die GAP hat ein helles grau-braune Farbe und Breite, flache Waage, vintage Strichzeichnung oder Gravur Abbildung.
 Gefallenen toten Baumstamm in einem Wald. Schleimigen weißen Pilze übernehmen Baumstumpf als Teil eines natürlichen Zersetzungsprozess Stockfotohttps://www.alamy.de/image-license-details/?v=1https://www.alamy.de/gefallenen-toten-baumstamm-in-einem-wald-schleimigen-weissen-pilze-ubernehmen-baumstumpf-als-teil-eines-naturlichen-zersetzungsprozess-image227651929.html
Gefallenen toten Baumstamm in einem Wald. Schleimigen weißen Pilze übernehmen Baumstumpf als Teil eines natürlichen Zersetzungsprozess Stockfotohttps://www.alamy.de/image-license-details/?v=1https://www.alamy.de/gefallenen-toten-baumstamm-in-einem-wald-schleimigen-weissen-pilze-ubernehmen-baumstumpf-als-teil-eines-naturlichen-zersetzungsprozess-image227651929.htmlRFR6ACA1–Gefallenen toten Baumstamm in einem Wald. Schleimigen weißen Pilze übernehmen Baumstumpf als Teil eines natürlichen Zersetzungsprozess
 Niedrigen Winkel Ansicht der Fliegenpilze im Regenwald Stock, Ecuador Stockfotohttps://www.alamy.de/image-license-details/?v=1https://www.alamy.de/stockfoto-niedrigen-winkel-ansicht-der-fliegenpilze-im-regenwald-stock-ecuador-56149852.html
Niedrigen Winkel Ansicht der Fliegenpilze im Regenwald Stock, Ecuador Stockfotohttps://www.alamy.de/image-license-details/?v=1https://www.alamy.de/stockfoto-niedrigen-winkel-ansicht-der-fliegenpilze-im-regenwald-stock-ecuador-56149852.htmlRFD79RKT–Niedrigen Winkel Ansicht der Fliegenpilze im Regenwald Stock, Ecuador
 Symbol Für Schwarzen Pilz Stock Vektorhttps://www.alamy.de/image-license-details/?v=1https://www.alamy.de/symbol-fur-schwarzen-pilz-image622886173.html
Symbol Für Schwarzen Pilz Stock Vektorhttps://www.alamy.de/image-license-details/?v=1https://www.alamy.de/symbol-fur-schwarzen-pilz-image622886173.htmlRF2Y5AWJN–Symbol Für Schwarzen Pilz
 Pilz. Stockfotohttps://www.alamy.de/image-license-details/?v=1https://www.alamy.de/pilz-image248344547.html
Pilz. Stockfotohttps://www.alamy.de/image-license-details/?v=1https://www.alamy.de/pilz-image248344547.htmlRFTC1203–Pilz.
 Exotische Shimenji Japanisch Pilze schließen sich in Studio Einstellung schwarz / weiß Stockfotohttps://www.alamy.de/image-license-details/?v=1https://www.alamy.de/stockfoto-exotische-shimenji-japanisch-pilze-schliessen-sich-in-studio-einstellung-schwarz-weiss-28871513.html
Exotische Shimenji Japanisch Pilze schließen sich in Studio Einstellung schwarz / weiß Stockfotohttps://www.alamy.de/image-license-details/?v=1https://www.alamy.de/stockfoto-exotische-shimenji-japanisch-pilze-schliessen-sich-in-studio-einstellung-schwarz-weiss-28871513.htmlRMBJY5WD–Exotische Shimenji Japanisch Pilze schließen sich in Studio Einstellung schwarz / weiß
 Morgen Pelikan zu schützen Stockfotohttps://www.alamy.de/image-license-details/?v=1https://www.alamy.de/stockfoto-morgen-pelikan-zu-schutzen-11197071.html
Morgen Pelikan zu schützen Stockfotohttps://www.alamy.de/image-license-details/?v=1https://www.alamy.de/stockfoto-morgen-pelikan-zu-schutzen-11197071.htmlRFA54R8G–Morgen Pelikan zu schützen
 Makro Pilz auf alten und toten Baumstumpf im Wald Stockfotohttps://www.alamy.de/image-license-details/?v=1https://www.alamy.de/makro-pilz-auf-alten-und-toten-baumstumpf-im-wald-image214760374.html
Makro Pilz auf alten und toten Baumstumpf im Wald Stockfotohttps://www.alamy.de/image-license-details/?v=1https://www.alamy.de/makro-pilz-auf-alten-und-toten-baumstumpf-im-wald-image214760374.htmlRFPDB51A–Makro Pilz auf alten und toten Baumstumpf im Wald
 Pilze im Wald Stockfotohttps://www.alamy.de/image-license-details/?v=1https://www.alamy.de/pilze-im-wald-image330921064.html
Pilze im Wald Stockfotohttps://www.alamy.de/image-license-details/?v=1https://www.alamy.de/pilze-im-wald-image330921064.htmlRF2A6AN5C–Pilze im Wald
 Pilze mit Herbstblättern in schwarz und weiß Stockfotohttps://www.alamy.de/image-license-details/?v=1https://www.alamy.de/pilze-mit-herbstblattern-in-schwarz-und-weiss-image487392751.html
Pilze mit Herbstblättern in schwarz und weiß Stockfotohttps://www.alamy.de/image-license-details/?v=1https://www.alamy.de/pilze-mit-herbstblattern-in-schwarz-und-weiss-image487392751.htmlRF2K8XJBY–Pilze mit Herbstblättern in schwarz und weiß
 Gönnen Sie sich eine Pause und entspannen Sie sich Stockfotohttps://www.alamy.de/image-license-details/?v=1https://www.alamy.de/gonnen-sie-sich-eine-pause-und-entspannen-sie-sich-image482835605.html
Gönnen Sie sich eine Pause und entspannen Sie sich Stockfotohttps://www.alamy.de/image-license-details/?v=1https://www.alamy.de/gonnen-sie-sich-eine-pause-und-entspannen-sie-sich-image482835605.htmlRF2K1F1MN–Gönnen Sie sich eine Pause und entspannen Sie sich
 Pilze Nahaufnahme schwarz-weiß Makro Stockfotohttps://www.alamy.de/image-license-details/?v=1https://www.alamy.de/stockfoto-pilze-nahaufnahme-schwarz-weiss-makro-140664847.html
Pilze Nahaufnahme schwarz-weiß Makro Stockfotohttps://www.alamy.de/image-license-details/?v=1https://www.alamy.de/stockfoto-pilze-nahaufnahme-schwarz-weiss-makro-140664847.htmlRFJ4RRCF–Pilze Nahaufnahme schwarz-weiß Makro
 Kastanienbraune Kappe. Pilz auf dem Waldboden mit Moos und Kiefernnadeln. Essbare Pilze im Wald gesammelt. Foto aus der Natur Stockfotohttps://www.alamy.de/image-license-details/?v=1https://www.alamy.de/kastanienbraune-kappe-pilz-auf-dem-waldboden-mit-moos-und-kiefernnadeln-essbare-pilze-im-wald-gesammelt-foto-aus-der-natur-image548106405.html
Kastanienbraune Kappe. Pilz auf dem Waldboden mit Moos und Kiefernnadeln. Essbare Pilze im Wald gesammelt. Foto aus der Natur Stockfotohttps://www.alamy.de/image-license-details/?v=1https://www.alamy.de/kastanienbraune-kappe-pilz-auf-dem-waldboden-mit-moos-und-kiefernnadeln-essbare-pilze-im-wald-gesammelt-foto-aus-der-natur-image548106405.htmlRF2PRMB8N–Kastanienbraune Kappe. Pilz auf dem Waldboden mit Moos und Kiefernnadeln. Essbare Pilze im Wald gesammelt. Foto aus der Natur
 Faulenden Baum Hintergrund Textur und close-up Stockfotohttps://www.alamy.de/image-license-details/?v=1https://www.alamy.de/faulenden-baum-hintergrund-textur-und-close-up-image601127960.html
Faulenden Baum Hintergrund Textur und close-up Stockfotohttps://www.alamy.de/image-license-details/?v=1https://www.alamy.de/faulenden-baum-hintergrund-textur-und-close-up-image601127960.htmlRM2WWYMRM–Faulenden Baum Hintergrund Textur und close-up
 Invertierte Kappen von Wildpilzen von weißer Farbe. Abstrakter Makrohintergrund. Unschärfe und selektiver Fokus. Stockfotohttps://www.alamy.de/image-license-details/?v=1https://www.alamy.de/invertierte-kappen-von-wildpilzen-von-weisser-farbe-abstrakter-makrohintergrund-unscharfe-und-selektiver-fokus-image608762006.html
Invertierte Kappen von Wildpilzen von weißer Farbe. Abstrakter Makrohintergrund. Unschärfe und selektiver Fokus. Stockfotohttps://www.alamy.de/image-license-details/?v=1https://www.alamy.de/invertierte-kappen-von-wildpilzen-von-weisser-farbe-abstrakter-makrohintergrund-unscharfe-und-selektiver-fokus-image608762006.htmlRF2XABE46–Invertierte Kappen von Wildpilzen von weißer Farbe. Abstrakter Makrohintergrund. Unschärfe und selektiver Fokus.
 Im Herbst unter dem Motto Bild mit Schnecke auf Pilz Wald mit Blättern und Moos Stockfotohttps://www.alamy.de/image-license-details/?v=1https://www.alamy.de/stockfoto-im-herbst-unter-dem-motto-bild-mit-schnecke-auf-pilz-wald-mit-blattern-und-moos-104979949.html
Im Herbst unter dem Motto Bild mit Schnecke auf Pilz Wald mit Blättern und Moos Stockfotohttps://www.alamy.de/image-license-details/?v=1https://www.alamy.de/stockfoto-im-herbst-unter-dem-motto-bild-mit-schnecke-auf-pilz-wald-mit-blattern-und-moos-104979949.htmlRFG2P6YW–Im Herbst unter dem Motto Bild mit Schnecke auf Pilz Wald mit Blättern und Moos
 King Oyster-Pilze sind fleischige Pilze, die zum Braten aufstehen. Sie haben eine pikante oder Umami-Qualität. Ein natürlicher Ersatz für Fleisch. Organisch Stockfotohttps://www.alamy.de/image-license-details/?v=1https://www.alamy.de/king-oyster-pilze-sind-fleischige-pilze-die-zum-braten-aufstehen-sie-haben-eine-pikante-oder-umami-qualitat-ein-naturlicher-ersatz-fur-fleisch-organisch-image484701582.html
King Oyster-Pilze sind fleischige Pilze, die zum Braten aufstehen. Sie haben eine pikante oder Umami-Qualität. Ein natürlicher Ersatz für Fleisch. Organisch Stockfotohttps://www.alamy.de/image-license-details/?v=1https://www.alamy.de/king-oyster-pilze-sind-fleischige-pilze-die-zum-braten-aufstehen-sie-haben-eine-pikante-oder-umami-qualitat-ein-naturlicher-ersatz-fur-fleisch-organisch-image484701582.htmlRM2K4G1PP–King Oyster-Pilze sind fleischige Pilze, die zum Braten aufstehen. Sie haben eine pikante oder Umami-Qualität. Ein natürlicher Ersatz für Fleisch. Organisch
 Frische Champignons liegen auf dem Tisch vor dem Hintergrund einer schwarz-weißen Ziegelwand-Nahaufnahme Stockfotohttps://www.alamy.de/image-license-details/?v=1https://www.alamy.de/frische-champignons-liegen-auf-dem-tisch-vor-dem-hintergrund-einer-schwarz-weissen-ziegelwand-nahaufnahme-image457997265.html
Frische Champignons liegen auf dem Tisch vor dem Hintergrund einer schwarz-weißen Ziegelwand-Nahaufnahme Stockfotohttps://www.alamy.de/image-license-details/?v=1https://www.alamy.de/frische-champignons-liegen-auf-dem-tisch-vor-dem-hintergrund-einer-schwarz-weissen-ziegelwand-nahaufnahme-image457997265.htmlRF2HH3G55–Frische Champignons liegen auf dem Tisch vor dem Hintergrund einer schwarz-weißen Ziegelwand-Nahaufnahme
 Schwarz-weißes Bild des Pilzes, der auf einem Baum gewachsen ist. Das Bild wurde aus dem niedrigen Winkel bis zur Spitze des Baumes aufgenommen, um es kreativ als Naturhintergrund und Copyspace zu verwenden. Stockfotohttps://www.alamy.de/image-license-details/?v=1https://www.alamy.de/schwarz-weisses-bild-des-pilzes-der-auf-einem-baum-gewachsen-ist-das-bild-wurde-aus-dem-niedrigen-winkel-bis-zur-spitze-des-baumes-aufgenommen-um-es-kreativ-als-naturhintergrund-und-copyspace-zu-verwenden-image439684241.html
Schwarz-weißes Bild des Pilzes, der auf einem Baum gewachsen ist. Das Bild wurde aus dem niedrigen Winkel bis zur Spitze des Baumes aufgenommen, um es kreativ als Naturhintergrund und Copyspace zu verwenden. Stockfotohttps://www.alamy.de/image-license-details/?v=1https://www.alamy.de/schwarz-weisses-bild-des-pilzes-der-auf-einem-baum-gewachsen-ist-das-bild-wurde-aus-dem-niedrigen-winkel-bis-zur-spitze-des-baumes-aufgenommen-um-es-kreativ-als-naturhintergrund-und-copyspace-zu-verwenden-image439684241.htmlRF2GF99MH–Schwarz-weißes Bild des Pilzes, der auf einem Baum gewachsen ist. Das Bild wurde aus dem niedrigen Winkel bis zur Spitze des Baumes aufgenommen, um es kreativ als Naturhintergrund und Copyspace zu verwenden.
 Pilze Stockfotohttps://www.alamy.de/image-license-details/?v=1https://www.alamy.de/stockfoto-pilze-167535169.html
Pilze Stockfotohttps://www.alamy.de/image-license-details/?v=1https://www.alamy.de/stockfoto-pilze-167535169.htmlRFKMFTPW–Pilze
 Pilze und Kleeblätter im Unterholz Stockfotohttps://www.alamy.de/image-license-details/?v=1https://www.alamy.de/pilze-und-kleeblatter-im-unterholz-image355982269.html
Pilze und Kleeblätter im Unterholz Stockfotohttps://www.alamy.de/image-license-details/?v=1https://www.alamy.de/pilze-und-kleeblatter-im-unterholz-image355982269.htmlRF2BK4B0D–Pilze und Kleeblätter im Unterholz
 Waldwald Stockfotohttps://www.alamy.de/image-license-details/?v=1https://www.alamy.de/waldwald-image447417255.html
Waldwald Stockfotohttps://www.alamy.de/image-license-details/?v=1https://www.alamy.de/waldwald-image447417255.htmlRF2GYWH7K–Waldwald
 Schnecke im Sommergarten Stockfotohttps://www.alamy.de/image-license-details/?v=1https://www.alamy.de/stockfoto-schnecke-im-sommergarten-80103754.html
Schnecke im Sommergarten Stockfotohttps://www.alamy.de/image-license-details/?v=1https://www.alamy.de/stockfoto-schnecke-im-sommergarten-80103754.htmlRFEJ914A–Schnecke im Sommergarten
 Eine rostige Metallstruktur, Textur aus rostigem Metall Stockfotohttps://www.alamy.de/image-license-details/?v=1https://www.alamy.de/eine-rostige-metallstruktur-textur-aus-rostigem-metall-image363078917.html
Eine rostige Metallstruktur, Textur aus rostigem Metall Stockfotohttps://www.alamy.de/image-license-details/?v=1https://www.alamy.de/eine-rostige-metallstruktur-textur-aus-rostigem-metall-image363078917.htmlRF2C2KJT5–Eine rostige Metallstruktur, Textur aus rostigem Metall
 Medium Format geschossen von Moos bedeckt Stubs. Stockfotohttps://www.alamy.de/image-license-details/?v=1https://www.alamy.de/stockfoto-medium-format-geschossen-von-moos-bedeckt-stubs-80486430.html
Medium Format geschossen von Moos bedeckt Stubs. Stockfotohttps://www.alamy.de/image-license-details/?v=1https://www.alamy.de/stockfoto-medium-format-geschossen-von-moos-bedeckt-stubs-80486430.htmlRFEJXD7A–Medium Format geschossen von Moos bedeckt Stubs.
 Boletus mushroom Silhouette auf weißem Hintergrund Stock Vektorhttps://www.alamy.de/image-license-details/?v=1https://www.alamy.de/stockfoto-boletus-mushroom-silhouette-auf-weissem-hintergrund-177176552.html
Boletus mushroom Silhouette auf weißem Hintergrund Stock Vektorhttps://www.alamy.de/image-license-details/?v=1https://www.alamy.de/stockfoto-boletus-mushroom-silhouette-auf-weissem-hintergrund-177176552.htmlRFM872E0–Boletus mushroom Silhouette auf weißem Hintergrund
 Kleine weiße ein Sonnenschirm in Sussex, UK Pilze Stockfotohttps://www.alamy.de/image-license-details/?v=1https://www.alamy.de/kleine-weisse-ein-sonnenschirm-in-sussex-uk-pilze-image66993123.html
Kleine weiße ein Sonnenschirm in Sussex, UK Pilze Stockfotohttps://www.alamy.de/image-license-details/?v=1https://www.alamy.de/kleine-weisse-ein-sonnenschirm-in-sussex-uk-pilze-image66993123.htmlRMDTYPBF–Kleine weiße ein Sonnenschirm in Sussex, UK Pilze
 Pilze im Wald Stockfotohttps://www.alamy.de/image-license-details/?v=1https://www.alamy.de/pilze-im-wald-image330921181.html
Pilze im Wald Stockfotohttps://www.alamy.de/image-license-details/?v=1https://www.alamy.de/pilze-im-wald-image330921181.htmlRF2A6AN9H–Pilze im Wald
 Graustufen selektive Fokusaufnahme eines Pilzes, der auf Laub wächst Holz Stockfotohttps://www.alamy.de/image-license-details/?v=1https://www.alamy.de/graustufen-selektive-fokusaufnahme-eines-pilzes-der-auf-laub-wachst-holz-image366137861.html
Graustufen selektive Fokusaufnahme eines Pilzes, der auf Laub wächst Holz Stockfotohttps://www.alamy.de/image-license-details/?v=1https://www.alamy.de/graustufen-selektive-fokusaufnahme-eines-pilzes-der-auf-laub-wachst-holz-image366137861.htmlRF2C7K0G5–Graustufen selektive Fokusaufnahme eines Pilzes, der auf Laub wächst Holz
 Kontinuierliche eine Linie Zeichnung des Pilzes. Vektorgrafik Stock Vektorhttps://www.alamy.de/image-license-details/?v=1https://www.alamy.de/kontinuierliche-eine-linie-zeichnung-des-pilzes-vektorgrafik-image480024071.html
Kontinuierliche eine Linie Zeichnung des Pilzes. Vektorgrafik Stock Vektorhttps://www.alamy.de/image-license-details/?v=1https://www.alamy.de/kontinuierliche-eine-linie-zeichnung-des-pilzes-vektorgrafik-image480024071.htmlRF2JTXYGR–Kontinuierliche eine Linie Zeichnung des Pilzes. Vektorgrafik
 Pilz-Graffiti mit schwarzer Sprühfarbe. Vektorabbildung. Stock Vektorhttps://www.alamy.de/image-license-details/?v=1https://www.alamy.de/pilz-graffiti-mit-schwarzer-spruhfarbe-vektorabbildung-image696691837.html
Pilz-Graffiti mit schwarzer Sprühfarbe. Vektorabbildung. Stock Vektorhttps://www.alamy.de/image-license-details/?v=1https://www.alamy.de/pilz-graffiti-mit-schwarzer-spruhfarbe-vektorabbildung-image696691837.htmlRF3CDD1F9–Pilz-Graffiti mit schwarzer Sprühfarbe. Vektorabbildung.
 Einfaches Vektor-Symbol für Pilze. Illustration Symbol Design-Vorlage für Web mobile UI-Element. Stock Vektorhttps://www.alamy.de/image-license-details/?v=1https://www.alamy.de/einfaches-vektor-symbol-fur-pilze-illustration-symbol-design-vorlage-fur-web-mobile-ui-element-image460731145.html
Einfaches Vektor-Symbol für Pilze. Illustration Symbol Design-Vorlage für Web mobile UI-Element. Stock Vektorhttps://www.alamy.de/image-license-details/?v=1https://www.alamy.de/einfaches-vektor-symbol-fur-pilze-illustration-symbol-design-vorlage-fur-web-mobile-ui-element-image460731145.htmlRF2HNG37N–Einfaches Vektor-Symbol für Pilze. Illustration Symbol Design-Vorlage für Web mobile UI-Element.
 Süße penny bun Pilz wächst im Gras. Die schöne kleine braune Kappe der Cep im Mittelpunkt. Es ist vegetarische Ernährung Essen. Der Pilz wächst Stock Vektorhttps://www.alamy.de/image-license-details/?v=1https://www.alamy.de/susse-penny-bun-pilz-wachst-im-gras-die-schone-kleine-braune-kappe-der-cep-im-mittelpunkt-es-ist-vegetarische-ernahrung-essen-der-pilz-wachst-image247720139.html
Süße penny bun Pilz wächst im Gras. Die schöne kleine braune Kappe der Cep im Mittelpunkt. Es ist vegetarische Ernährung Essen. Der Pilz wächst Stock Vektorhttps://www.alamy.de/image-license-details/?v=1https://www.alamy.de/susse-penny-bun-pilz-wachst-im-gras-die-schone-kleine-braune-kappe-der-cep-im-mittelpunkt-es-ist-vegetarische-ernahrung-essen-der-pilz-wachst-image247720139.htmlRFTB0HFR–Süße penny bun Pilz wächst im Gras. Die schöne kleine braune Kappe der Cep im Mittelpunkt. Es ist vegetarische Ernährung Essen. Der Pilz wächst
 Pilz-Symbol braune Umrandung für illustration Stock Vektorhttps://www.alamy.de/image-license-details/?v=1https://www.alamy.de/stockfoto-pilz-symbol-braune-umrandung-fur-illustration-115826621.html
Pilz-Symbol braune Umrandung für illustration Stock Vektorhttps://www.alamy.de/image-license-details/?v=1https://www.alamy.de/stockfoto-pilz-symbol-braune-umrandung-fur-illustration-115826621.htmlRFGMCA11–Pilz-Symbol braune Umrandung für illustration
 Wasserkaskaden über Mossy Rocks in Schwarz und Weiß Stockfotohttps://www.alamy.de/image-license-details/?v=1https://www.alamy.de/wasserkaskaden-uber-mossy-rocks-in-schwarz-und-weiss-image408039233.html
Wasserkaskaden über Mossy Rocks in Schwarz und Weiß Stockfotohttps://www.alamy.de/image-license-details/?v=1https://www.alamy.de/wasserkaskaden-uber-mossy-rocks-in-schwarz-und-weiss-image408039233.htmlRF2EKRP5N–Wasserkaskaden über Mossy Rocks in Schwarz und Weiß
 Ein Landsmann überprüfen ein riesiges Puffball (Calvatia gigantea - früher als Lycoperdon giganteum). Bovisten sind Pilze, so genannt, weil Wolken der braune Staub - wie Sporen aus, wenn der Reifen platzt oder fruitbody betroffen sind. Es kann zu einem Fuß (30 cm) oder mehr im Durchmesser, und ist schwer zu Fehler für alle anderen Pilz. Es ist geschätzt worden, dass ein großes Stück von diesem Pilz, wenn fällig wird um 7 × 10¹² Sporen produzieren. Wenn gesammelt, bevor Sporen gebildet haben, während das Fleisch noch weiß ist, Es kann gekocht werden als Schichten in Butter gebraten, mit einem starken, Pilz, erdigen Geschmack. Stockfotohttps://www.alamy.de/image-license-details/?v=1https://www.alamy.de/ein-landsmann-uberprufen-ein-riesiges-puffball-calvatia-gigantea-fruher-als-lycoperdon-giganteum-bovisten-sind-pilze-so-genannt-weil-wolken-der-braune-staub-wie-sporen-aus-wenn-der-reifen-platzt-oder-fruitbody-betroffen-sind-es-kann-zu-einem-fuss-30-cm-oder-mehr-im-durchmesser-und-ist-schwer-zu-fehler-fur-alle-anderen-pilz-es-ist-geschatzt-worden-dass-ein-grosses-stuck-von-diesem-pilz-wenn-fallig-wird-um-7-10-sporen-produzieren-wenn-gesammelt-bevor-sporen-gebildet-haben-wahrend-das-fleisch-noch-weiss-ist-es-kann-gekocht-werden-als-schichten-in-butter-gebraten-mit-einem-starken-pilz-erdigen-geschmack-image338281231.html
Ein Landsmann überprüfen ein riesiges Puffball (Calvatia gigantea - früher als Lycoperdon giganteum). Bovisten sind Pilze, so genannt, weil Wolken der braune Staub - wie Sporen aus, wenn der Reifen platzt oder fruitbody betroffen sind. Es kann zu einem Fuß (30 cm) oder mehr im Durchmesser, und ist schwer zu Fehler für alle anderen Pilz. Es ist geschätzt worden, dass ein großes Stück von diesem Pilz, wenn fällig wird um 7 × 10¹² Sporen produzieren. Wenn gesammelt, bevor Sporen gebildet haben, während das Fleisch noch weiß ist, Es kann gekocht werden als Schichten in Butter gebraten, mit einem starken, Pilz, erdigen Geschmack. Stockfotohttps://www.alamy.de/image-license-details/?v=1https://www.alamy.de/ein-landsmann-uberprufen-ein-riesiges-puffball-calvatia-gigantea-fruher-als-lycoperdon-giganteum-bovisten-sind-pilze-so-genannt-weil-wolken-der-braune-staub-wie-sporen-aus-wenn-der-reifen-platzt-oder-fruitbody-betroffen-sind-es-kann-zu-einem-fuss-30-cm-oder-mehr-im-durchmesser-und-ist-schwer-zu-fehler-fur-alle-anderen-pilz-es-ist-geschatzt-worden-dass-ein-grosses-stuck-von-diesem-pilz-wenn-fallig-wird-um-7-10-sporen-produzieren-wenn-gesammelt-bevor-sporen-gebildet-haben-wahrend-das-fleisch-noch-weiss-ist-es-kann-gekocht-werden-als-schichten-in-butter-gebraten-mit-einem-starken-pilz-erdigen-geschmack-image338281231.htmlRM2AJA14F–Ein Landsmann überprüfen ein riesiges Puffball (Calvatia gigantea - früher als Lycoperdon giganteum). Bovisten sind Pilze, so genannt, weil Wolken der braune Staub - wie Sporen aus, wenn der Reifen platzt oder fruitbody betroffen sind. Es kann zu einem Fuß (30 cm) oder mehr im Durchmesser, und ist schwer zu Fehler für alle anderen Pilz. Es ist geschätzt worden, dass ein großes Stück von diesem Pilz, wenn fällig wird um 7 × 10¹² Sporen produzieren. Wenn gesammelt, bevor Sporen gebildet haben, während das Fleisch noch weiß ist, Es kann gekocht werden als Schichten in Butter gebraten, mit einem starken, Pilz, erdigen Geschmack.
 Frische Champignons liegen auf dem Tisch vor dem Hintergrund einer schwarz-weißen Ziegelwand-Nahaufnahme Stockfotohttps://www.alamy.de/image-license-details/?v=1https://www.alamy.de/frische-champignons-liegen-auf-dem-tisch-vor-dem-hintergrund-einer-schwarz-weissen-ziegelwand-nahaufnahme-image460184420.html
Frische Champignons liegen auf dem Tisch vor dem Hintergrund einer schwarz-weißen Ziegelwand-Nahaufnahme Stockfotohttps://www.alamy.de/image-license-details/?v=1https://www.alamy.de/frische-champignons-liegen-auf-dem-tisch-vor-dem-hintergrund-einer-schwarz-weissen-ziegelwand-nahaufnahme-image460184420.htmlRF2HMK5WT–Frische Champignons liegen auf dem Tisch vor dem Hintergrund einer schwarz-weißen Ziegelwand-Nahaufnahme
 Einfarbige Vektorgrafik der jungen Schild Pilzzucht von totem Holz von der Seite. Stock Vektorhttps://www.alamy.de/image-license-details/?v=1https://www.alamy.de/einfarbige-vektorgrafik-der-jungen-schild-pilzzucht-von-totem-holz-von-der-seite-image226429057.html
Einfarbige Vektorgrafik der jungen Schild Pilzzucht von totem Holz von der Seite. Stock Vektorhttps://www.alamy.de/image-license-details/?v=1https://www.alamy.de/einfarbige-vektorgrafik-der-jungen-schild-pilzzucht-von-totem-holz-von-der-seite-image226429057.htmlRFR4AMG1–Einfarbige Vektorgrafik der jungen Schild Pilzzucht von totem Holz von der Seite.
 regenbogenfarbene, mehrschichtige Baumpilze Stockfotohttps://www.alamy.de/image-license-details/?v=1https://www.alamy.de/regenbogenfarbene-mehrschichtige-baumpilze-image604300580.html
regenbogenfarbene, mehrschichtige Baumpilze Stockfotohttps://www.alamy.de/image-license-details/?v=1https://www.alamy.de/regenbogenfarbene-mehrschichtige-baumpilze-image604300580.htmlRF2X347FG–regenbogenfarbene, mehrschichtige Baumpilze
 Gesundes Essen auf den Tisch. Nahaufnahme auf moderne Frau Koch Schürze tragen auf Gelb mit einem jar von marinierten Pilzen isoliert Stockfotohttps://www.alamy.de/image-license-details/?v=1https://www.alamy.de/stockfoto-gesundes-essen-auf-den-tisch-nahaufnahme-auf-moderne-frau-koch-schurze-tragen-auf-gelb-mit-einem-jar-von-marinierten-pilzen-isoliert-170725145.html
Gesundes Essen auf den Tisch. Nahaufnahme auf moderne Frau Koch Schürze tragen auf Gelb mit einem jar von marinierten Pilzen isoliert Stockfotohttps://www.alamy.de/image-license-details/?v=1https://www.alamy.de/stockfoto-gesundes-essen-auf-den-tisch-nahaufnahme-auf-moderne-frau-koch-schurze-tragen-auf-gelb-mit-einem-jar-von-marinierten-pilzen-isoliert-170725145.htmlRFKWN5JH–Gesundes Essen auf den Tisch. Nahaufnahme auf moderne Frau Koch Schürze tragen auf Gelb mit einem jar von marinierten Pilzen isoliert
 Waldwald Stockfotohttps://www.alamy.de/image-license-details/?v=1https://www.alamy.de/waldwald-image447417252.html
Waldwald Stockfotohttps://www.alamy.de/image-license-details/?v=1https://www.alamy.de/waldwald-image447417252.htmlRF2GYWH7G–Waldwald
 Schnecke im Sommergarten Stockfotohttps://www.alamy.de/image-license-details/?v=1https://www.alamy.de/stockfoto-schnecke-im-sommergarten-80103749.html
Schnecke im Sommergarten Stockfotohttps://www.alamy.de/image-license-details/?v=1https://www.alamy.de/stockfoto-schnecke-im-sommergarten-80103749.htmlRFEJ9145–Schnecke im Sommergarten
 Nahtloses Muster mit Vektorpilzen und Blättern Stockfotohttps://www.alamy.de/image-license-details/?v=1https://www.alamy.de/nahtloses-muster-mit-vektorpilzen-und-blattern-image620270084.html
Nahtloses Muster mit Vektorpilzen und Blättern Stockfotohttps://www.alamy.de/image-license-details/?v=1https://www.alamy.de/nahtloses-muster-mit-vektorpilzen-und-blattern-image620270084.htmlRF2Y13MR0–Nahtloses Muster mit Vektorpilzen und Blättern
 Set von Silhouetten von essbaren Pilzen, Vektor-Illustration Stock Vektorhttps://www.alamy.de/image-license-details/?v=1https://www.alamy.de/set-von-silhouetten-von-essbaren-pilzen-vektor-illustration-image455886363.html
Set von Silhouetten von essbaren Pilzen, Vektor-Illustration Stock Vektorhttps://www.alamy.de/image-license-details/?v=1https://www.alamy.de/set-von-silhouetten-von-essbaren-pilzen-vektor-illustration-image455886363.htmlRF2HDKBKR–Set von Silhouetten von essbaren Pilzen, Vektor-Illustration
 Boletus mushroom Umrisse auf weißem Hintergrund Stock Vektorhttps://www.alamy.de/image-license-details/?v=1https://www.alamy.de/stockfoto-boletus-mushroom-umrisse-auf-weissem-hintergrund-177176555.html
Boletus mushroom Umrisse auf weißem Hintergrund Stock Vektorhttps://www.alamy.de/image-license-details/?v=1https://www.alamy.de/stockfoto-boletus-mushroom-umrisse-auf-weissem-hintergrund-177176555.htmlRFM872E3–Boletus mushroom Umrisse auf weißem Hintergrund
 Satz von verschiedenen Waldpilzen. Stock Vektorhttps://www.alamy.de/image-license-details/?v=1https://www.alamy.de/stockfoto-satz-von-verschiedenen-waldpilzen-90943731.html
Satz von verschiedenen Waldpilzen. Stock Vektorhttps://www.alamy.de/image-license-details/?v=1https://www.alamy.de/stockfoto-satz-von-verschiedenen-waldpilzen-90943731.htmlRFF7XRJB–Satz von verschiedenen Waldpilzen.
 Pilzsymbol flach. Schwarzes Piktogramm auf grauem Hintergrund. Symbol für Vektorgrafik Stock Vektorhttps://www.alamy.de/image-license-details/?v=1https://www.alamy.de/pilzsymbol-flach-schwarzes-piktogramm-auf-grauem-hintergrund-symbol-fur-vektorgrafik-image360036510.html
Pilzsymbol flach. Schwarzes Piktogramm auf grauem Hintergrund. Symbol für Vektorgrafik Stock Vektorhttps://www.alamy.de/image-license-details/?v=1https://www.alamy.de/pilzsymbol-flach-schwarzes-piktogramm-auf-grauem-hintergrund-symbol-fur-vektorgrafik-image360036510.htmlRF2BWN26P–Pilzsymbol flach. Schwarzes Piktogramm auf grauem Hintergrund. Symbol für Vektorgrafik
 Ein einzelner kleiner Pilz, der auf dem Boden wächst, isoliert von anderen Vegetationen Stockfotohttps://www.alamy.de/image-license-details/?v=1https://www.alamy.de/ein-einzelner-kleiner-pilz-der-auf-dem-boden-wachst-isoliert-von-anderen-vegetationen-image554698016.html
Ein einzelner kleiner Pilz, der auf dem Boden wächst, isoliert von anderen Vegetationen Stockfotohttps://www.alamy.de/image-license-details/?v=1https://www.alamy.de/ein-einzelner-kleiner-pilz-der-auf-dem-boden-wachst-isoliert-von-anderen-vegetationen-image554698016.htmlRF2R6CJYC–Ein einzelner kleiner Pilz, der auf dem Boden wächst, isoliert von anderen Vegetationen
 Pilzsymbol flach. Schwarzes Piktogramm auf weißem Hintergrund. Vektorgrafik Symbol und Bonus-Taste Stock Vektorhttps://www.alamy.de/image-license-details/?v=1https://www.alamy.de/pilzsymbol-flach-schwarzes-piktogramm-auf-weissem-hintergrund-vektorgrafik-symbol-und-bonus-taste-image388152904.html
Pilzsymbol flach. Schwarzes Piktogramm auf weißem Hintergrund. Vektorgrafik Symbol und Bonus-Taste Stock Vektorhttps://www.alamy.de/image-license-details/?v=1https://www.alamy.de/pilzsymbol-flach-schwarzes-piktogramm-auf-weissem-hintergrund-vektorgrafik-symbol-und-bonus-taste-image388152904.htmlRF2DFDTYM–Pilzsymbol flach. Schwarzes Piktogramm auf weißem Hintergrund. Vektorgrafik Symbol und Bonus-Taste
 Pilz-Graffiti mit schwarzer Sprühfarbe. Vektorabbildung. Stock Vektorhttps://www.alamy.de/image-license-details/?v=1https://www.alamy.de/pilz-graffiti-mit-schwarzer-spruhfarbe-vektorabbildung-image696691903.html
Pilz-Graffiti mit schwarzer Sprühfarbe. Vektorabbildung. Stock Vektorhttps://www.alamy.de/image-license-details/?v=1https://www.alamy.de/pilz-graffiti-mit-schwarzer-spruhfarbe-vektorabbildung-image696691903.htmlRF3CDD1HK–Pilz-Graffiti mit schwarzer Sprühfarbe. Vektorabbildung.
 Waldpilz im Gras. Handgezeichnete Linienzeichnung im gravierten Doodle-Stil. Isolierter Vektor. Vegetarische Herbstgerichte. Braune Kappe oder orangefarbene Tasse Boletus. Botanische Zeichnung mit Striche. Stock Vektorhttps://www.alamy.de/image-license-details/?v=1https://www.alamy.de/waldpilz-im-gras-handgezeichnete-linienzeichnung-im-gravierten-doodle-stil-isolierter-vektor-vegetarische-herbstgerichte-braune-kappe-oder-orangefarbene-tasse-boletus-botanische-zeichnung-mit-striche-image386930656.html
Waldpilz im Gras. Handgezeichnete Linienzeichnung im gravierten Doodle-Stil. Isolierter Vektor. Vegetarische Herbstgerichte. Braune Kappe oder orangefarbene Tasse Boletus. Botanische Zeichnung mit Striche. Stock Vektorhttps://www.alamy.de/image-license-details/?v=1https://www.alamy.de/waldpilz-im-gras-handgezeichnete-linienzeichnung-im-gravierten-doodle-stil-isolierter-vektor-vegetarische-herbstgerichte-braune-kappe-oder-orangefarbene-tasse-boletus-botanische-zeichnung-mit-striche-image386930656.htmlRF2DDE600–Waldpilz im Gras. Handgezeichnete Linienzeichnung im gravierten Doodle-Stil. Isolierter Vektor. Vegetarische Herbstgerichte. Braune Kappe oder orangefarbene Tasse Boletus. Botanische Zeichnung mit Striche.
 Pilz-Graffiti mit schwarzer Sprühfarbe. Vektorabbildung. Stock Vektorhttps://www.alamy.de/image-license-details/?v=1https://www.alamy.de/pilz-graffiti-mit-schwarzer-spruhfarbe-vektorabbildung-image672215704.html
Pilz-Graffiti mit schwarzer Sprühfarbe. Vektorabbildung. Stock Vektorhttps://www.alamy.de/image-license-details/?v=1https://www.alamy.de/pilz-graffiti-mit-schwarzer-spruhfarbe-vektorabbildung-image672215704.htmlRF3B1J1YM–Pilz-Graffiti mit schwarzer Sprühfarbe. Vektorabbildung.
 Pilz-Symbol braune Umrandung für illustration Stock Vektorhttps://www.alamy.de/image-license-details/?v=1https://www.alamy.de/stockfoto-pilz-symbol-braune-umrandung-fur-illustration-115826594.html
Pilz-Symbol braune Umrandung für illustration Stock Vektorhttps://www.alamy.de/image-license-details/?v=1https://www.alamy.de/stockfoto-pilz-symbol-braune-umrandung-fur-illustration-115826594.htmlRFGMCA02–Pilz-Symbol braune Umrandung für illustration
 In der Nähe von low level Blick auf Wilden britischen Wald Pilze Stockfotohttps://www.alamy.de/image-license-details/?v=1https://www.alamy.de/in-der-nahe-von-low-level-blick-auf-wilden-britischen-wald-pilze-image332620122.html
In der Nähe von low level Blick auf Wilden britischen Wald Pilze Stockfotohttps://www.alamy.de/image-license-details/?v=1https://www.alamy.de/in-der-nahe-von-low-level-blick-auf-wilden-britischen-wald-pilze-image332620122.htmlRF2A944A2–In der Nähe von low level Blick auf Wilden britischen Wald Pilze
Pflasterpilz (Agaricus bitorquis), Fungi, Charles St, Cambridge, MA, US, wächst aus einem Riss zwischen dem Bürgersteig und einer Wand 15 cm Kappendurchmesser Brauner Sporendruck durchschnittlicher Sporendruck 4.9μm x 4.3μm Stockfotohttps://www.alamy.de/image-license-details/?v=1https://www.alamy.de/pflasterpilz-agaricus-bitorquis-fungi-charles-st-cambridge-ma-us-wachst-aus-einem-riss-zwischen-dem-burgersteig-und-einer-wand-15-cm-kappendurchmesser-brauner-sporendruck-durchschnittlicher-sporendruck-49m-x-43m-image652288141.html
Pflasterpilz (Agaricus bitorquis), Fungi, Charles St, Cambridge, MA, US, wächst aus einem Riss zwischen dem Bürgersteig und einer Wand 15 cm Kappendurchmesser Brauner Sporendruck durchschnittlicher Sporendruck 4.9μm x 4.3μm Stockfotohttps://www.alamy.de/image-license-details/?v=1https://www.alamy.de/pflasterpilz-agaricus-bitorquis-fungi-charles-st-cambridge-ma-us-wachst-aus-einem-riss-zwischen-dem-burgersteig-und-einer-wand-15-cm-kappendurchmesser-brauner-sporendruck-durchschnittlicher-sporendruck-49m-x-43m-image652288141.htmlRM2SW6851–Pflasterpilz (Agaricus bitorquis), Fungi, Charles St, Cambridge, MA, US, wächst aus einem Riss zwischen dem Bürgersteig und einer Wand 15 cm Kappendurchmesser Brauner Sporendruck durchschnittlicher Sporendruck 4.9μm x 4.3μm
 Schwarz-weißes Foto des putenschwanzes (trametes versicolor), der auf einem gefallenen Baum im Wald wächst Stockfotohttps://www.alamy.de/image-license-details/?v=1https://www.alamy.de/schwarz-weisses-foto-des-putenschwanzes-trametes-versicolor-der-auf-einem-gefallenen-baum-im-wald-wachst-image460848449.html
Schwarz-weißes Foto des putenschwanzes (trametes versicolor), der auf einem gefallenen Baum im Wald wächst Stockfotohttps://www.alamy.de/image-license-details/?v=1https://www.alamy.de/schwarz-weisses-foto-des-putenschwanzes-trametes-versicolor-der-auf-einem-gefallenen-baum-im-wald-wachst-image460848449.htmlRF2HNNCW5–Schwarz-weißes Foto des putenschwanzes (trametes versicolor), der auf einem gefallenen Baum im Wald wächst